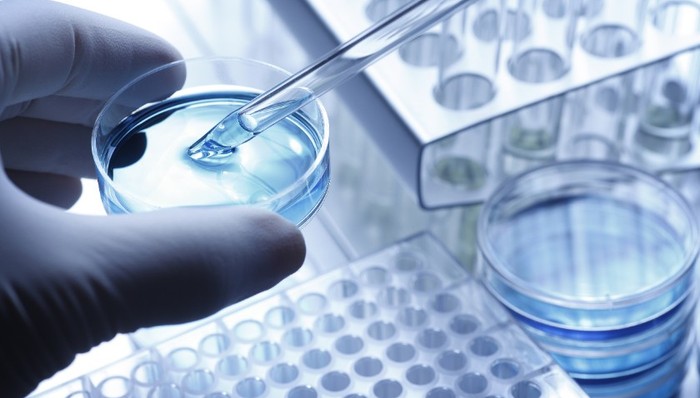
泓博智源,环保处罚,研发投入

实习记者 | 梁怡
2020年3月8日,上海泓博智源医药股份有限公司(简称“泓博智源”)拟冲刺创业板IPO,本次拟公开发行股票的总量不超过1,925万股,预计融资金额4.7707(亿元),保荐机构为中信证券。
泓博智源是一家新药研发以及商业化生产一站式的综合服务商,致力于药物发现、制药工艺的研究开发以及原料药中间体的商业化生产。泓博智源的主营业务主要涵盖药物发现(CRO)、工艺研究与开发 (CRO/CDMO)以及商业化生产(含CMO)。
其中,药物发现包括药物化学研究、合成化学研究以及药物代谢动力学研究;工艺研究与开发包括工艺化学和工艺开发以及原料药 CMC 研究;商业化生产包括新药定制化生产(CMO)及自主仿制药产品的研发、生产及销售。
国内市场核心竞争力不足

从2017年~2020年1-9月以来,公司国外地区销售收入占主营业务收入的比重分别为 82.46%、79.82%、81.28%和 80.65%,说明泓博智源的主营业务收入集中在国外地区,并且以美国及印度为主,而国内市场占率有不足。
相关资料显示,现阶段国内CRO市场持续快速发展,国内CRO企业快速成长。例如药明康德,作为龙头行业,其服务范围覆盖从概念产生到商业化生产的整个流程,客户囊括多家国际知名大型药企。其次,随着行业改革政策,仿制药利润空间被大幅压缩,未来医药行业将逐步分化,龙头企业头部效应更加明显。最后,全球大部分CRO龙头企业在中国有所布局,国外龙头企业的分支机构也成了国内市场的一股主要竞争力量,因此国内CRO市场竞争加剧。
界面记者还发现,从2019年以来,泓博智源的研发费用率略低于同行业可比公司,研发投入占比下降。泓博智源也表示公司的研发团队相较于国内龙头药明康德、康龙化成,服务规模相对偏小,难以满足大型跨国药企和国内大型药业集团创新药研发及商业化生产的部分业务需求。
资产负债率高于同行
据招股书显示,在2019年及2020年1-9月中,泓博智源的流动比率、速动比率略低于可比公司平均值,而从2019年开始,资产负债率略高于可比公司平均值。泓博智源对此表示,主要因为公司未上市,以债权融资为主,与同行业上市公司相比,融资渠道有限。
界面记者注意到,本次IPO预计募投资金约4.7707亿元。其中用于临床前新药研发基地建设项目为38,706.89万元;补充流动资金为9,000.00万元,占募投总资金的近1/4。
界面新闻记者还发现,泓博智源存在固定资产用于抵押借款的情况。2019年12月26日,上海泓博与中国银行股份有限公司上海市南汇支行签订《流动资金借款合同》借款480.00万元,并签订《最高额抵押合同》,以上海泓博拥有的8台设备进行抵押,抵押设备账面原值共1,052.59万元。
子公司多次受到行政处罚
目前泓博智源拥有2家全资子公司,一家为泓博智源(开原)药业有限公司(简称“开原泓博”),主要承担公司的商业化生产业务,另一家为苏州景泓生物技术有限公司(简称“苏州景泓”),主要从事技术服务及进出口业务。
据招股书显示,子公司开原泓博因环保设施未正常运行、废气排放超标等原因,受到环保部门共5次行政处罚,涉及处罚金额共计41.24万元;同时,开原泓博因员工违章操作发生1起一般生产安全责任事故,受到安全生产监督部门行政处罚,涉及处罚金额30万元,6次行政处罚累计金额共71.24万元。
针对上述环保和安全处罚,泓博智源表示已经进行了整改,包括制定了严格的环保及安全管理制度,并在污染治理上加大投入,不断优化工艺及设备,并根据生产需要适时引进新的环保设备。但其还表示,尽管已经做好相应的防治措施,公司仍存在由于不能达到环保要求或发生环保或安全生产事故而被有关部门处罚的可能,因此做出相应的环保及安全生产风险提示。

评论